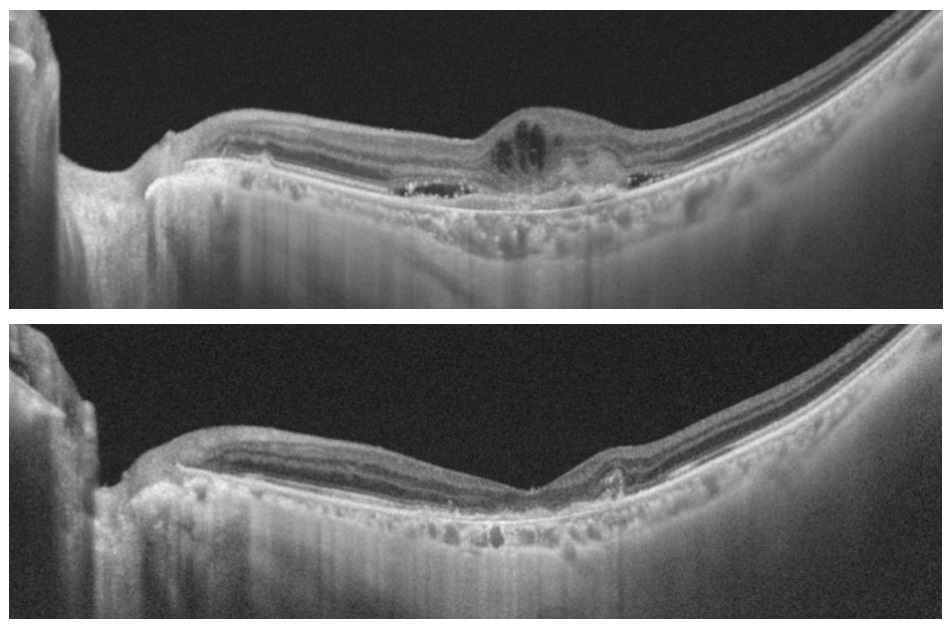
Photo_黄斑疾患総合ケアユニット_No.2

黄斑疾患総合ケアユニット
人間の眼はカメラによく例えられますが、そのフィルムに相当する網膜の中心部分が黄斑です(図1)。黄斑は視力を担う、いわば視覚の中枢とも言える部位であり、その障害は患者さんのQOLの低下に直結します。
図1:黄斑は人間の網膜の中枢部分にあたる非常に重要な部位です


黄斑疾患、とりわけ加齢黄斑変性や糖尿病網膜症は社会的失明の主原因であり、現在本邦でも急激に増加しています。黄斑疾患総合ケアユニットでは糖尿病眼科と連携の元、多岐にわたる黄斑疾患に対し、最先端の診断機器を駆使した的確な診断と、それに基づいた高度の内科的、外科的治療を提供して参ります(図2)。また当ユニットで行われている研究に関しても世界トップレベルの内容であると自負しており、今後も精力的に新規の診断法、治療法の開発に取り組んでいく所存です。
図2:滲出型加齢黄斑変性に対する抗血管内皮増殖因子(VEGF)剤による治療
光干渉断層計(OCT)で治療前にみられた網膜の浮腫(上図)が治療後には消失しています(下図)

■ 黄斑・網膜硝子体外来 担当医師
飯田 知弘 丸子 一朗 長谷川 泰司 荒川 久弥
■ 黄斑・網膜硝子体外来 診療日
月曜日・木曜日 午前午後、水曜日 午前
※予約受付電話:03(3353)8138







